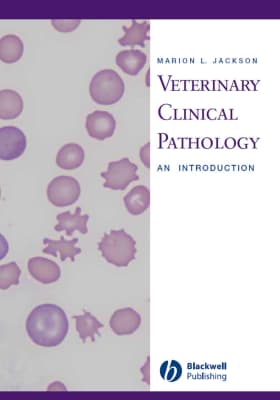

Fundamentals Of Veterinary Clinical Pathology
| Use attributes for filter ! | |
| Google books | books.google.com |
|---|---|
| Originally published | October 4, 2002 |
| Authors | Steven L. Stockham |
| Michael A. Scott | |
| Editors | Michael A. Scott |
| Published | October 4, 2002 |
| Media actions | www.worldcat.org |
| Get book actions | www.worldcat.org |
| Date of Reg. | |
| Date of Upd. | |
| ID | 2109997 |
About Fundamentals Of Veterinary Clinical Pathology
This book provides in-depth information about common clinical laboratory assays that are used to evaluate domestic mammals, including what assays measure, sample or assay conditions that affect results, and what results indicate about the physiologic or pathologic state of a patient. ...